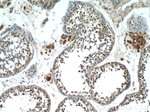
HSFY1 Antibody in Immunohistochemistry (Paraffin) (IHC (P))

Search
Proteintech
HSFY1 Polyclonal Antibody
{{$productOrderCtrl.translations['antibody.pdp.commerceCard.promotion.promotions']}}
{{$productOrderCtrl.translations['antibody.pdp.commerceCard.promotion.viewpromo']}}
{{$productOrderCtrl.translations['antibody.pdp.commerceCard.promotion.promocode']}}: {{promo.promoCode}} {{promo.promoTitle}} {{promo.promoDescription}}. {{$productOrderCtrl.translations['antibody.pdp.commerceCard.promotion.learnmore']}}
产品信息
11970-1-AP
种属反应
宿主/亚型
分类
类型
抗原
偶联物
形式
浓度
规格
纯化类型
保存液
内含物
保存条件
运输条件
产品详细信息
Immunogen sequence: MAHVSSETQ DVSPKDELTA SEASTRSPLC EHTFPGDSDL RSMIEEHAFQ VLSQGSLLES PSYTVCVSEP DKDDDFLSLN FPRKLWKIVE SDQFKSISWD ENGTCIVINE ELFKKEILET KAPYRIFQTD AIKSFVRQLN LYGFSKIQQN FQRSAFLATF LSEEKESSVL SKLHVFVFHH SLFGATFGEH HFQPCPLPSG NKAPISTWSG DSWLL (1-214 aa encoded by BC055414)
靶标信息
This gene encodes a member of the heat shock factor (HSF) family of transcriptional activators for heat shock proteins. This gene is a candidate gene for azoospermia, since it localizes to a region of chromosome Y that is sometimes deleted in infertile males. The genome has two identical copies of this gene within a palindromic region; this record represents the more centromeric copy. Alternative splicing results in multiple transcript variants encoding distinct isoforms.
仅用于科研。不用于诊断过程。未经明确授权不得转售。
篇参考文献 (0)
生物信息学
蛋白别名: Heat shock transcription factor 2-like protein; Heat shock transcription factor, Y-linked; HSF2-like; Y-linked 1
基因别名: HSF2L; HSFY; HSFY1; HSFY2
UniProt ID: (Human) Q96LI6
Entrez Gene ID: (Human) 86614